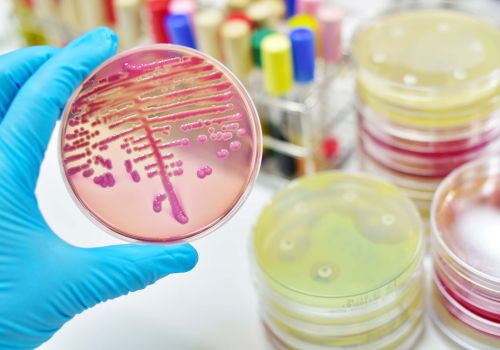

Abrir en el navegador
Abrir en el navegador
|

|

|
Entrevistas
|

|
Eva Ortega-Paíno
Directora Científica del Biobanco en CNIO
Facilitar el acceso de los investigadores a las muestras biológicas, y su información asociada, son pilares clave en...
Continuar leyendo
|
|

|
Noticias destacadas
|

|
BIOSPAIN 2023 cierra su undécima edición con cifras récord de participación
El Encuentro Internacional de Biotecnología BIOSPAIN 2023, que se ha celebrado el 26 al 28 de septiembre en la Fira de Barcelona...
Continuar leyendo
|
|

|

|
Farmaforum premia a los grandes representantes de la industria biofarmacéutica en nuestro país
El evento anual más esperado en la industria farmacéutica, Farmaforum, tuvo lugar los días 20 y 21 de septiembre...
Continuar leyendo
|
|

|
AseBio Te cuenta
|

|
Resistencia a los antimicrobianos: “Europa podría sufrir un retroceso a la era anterior a los antibióticos”
La resistencia a los antibióticos ha sido declarada por la Organización Mundial de la Salud (OMS) como una...
Continuar leyendo
|
|

|
Bioga Comunica
|

|
AllGenetics celebra su 12º aniversario consolidando su posición como proveedor líder de servicios genómicos en Europa
Fundada en 2011 en la incubadora de empresas de la Universidade da Coruña, la empresa no ha dejado de crecer a lo largo de los años....
Continuar leyendo
|
|

|
Actualidad de Farmabiotec
|

|
Constituido el jurado de los premios Zendal que se entregarán en el mes de noviembre en una gala en Vigo
El jurado de los premios Zendal, que otorga el grupo biotecnológico Zendal, ha quedado constituido para poder evaluar las candidaturas,...
Continuar leyendo
|
|

|

|
La industria biotecnológica es ya un actor clave en la lucha contra las resistencias antimicrobianas y el abordaje de enfermedades raras
Con más de 300 medicamentos aprobados para alrededor de 250 indicaciones, y un millar de moléculas en distintas fases de investigación...
Continuar leyendo
|
|

|
Las ayudas a la investigación de la Fundación Soria Melguizo destinarán 600.000 euros a proyectos sobre resistencias a antimicrobianos y gerotecnología
La Fundación Francisco Soria Melguizo acaba de lanzar la convocatoria de sus Ayudas a la Investigación Biomédica 2023,...
Continuar leyendo
|
|

|

|
La doctora Milana Arantza Bergamino, del Instituto Catalán de Oncología de Badalona, ganadora del II Premio a la Tesis Doctoral de Medicina Personalizada de Precisión para Investigadores Jóvenes
La doctora Milana Arantza Bergamino Sirvén, oncóloga médica del Instituto Catalán de Oncología (ICO)...
Continuar leyendo
|
|

|
Sale a la luz el mecanismo que explicaría por qué el ADN mitocondrial sólo se hereda de la madre
Un rasgo evolutivo de los humanos y de la mayoría de animales es que heredan el ADN mitocondrial exclusivamente de la madre, a pesar...
Continuar leyendo
|
|

|

|
Un estudio aborda la función de las bacterias intestinales para desarrollar nuevos probióticos
Los microorganismos que habitan en el intestino (microbiota) actúan como un biorreactor que metaboliza los nutrientes que nuestro...
Continuar leyendo
|
|

|
La revisión de la legislación farmacéutica europea, una oportunidad para optimizar la regulación de la exención hospitalaria para terapias avanzadas
La revisión de la legislación farmacéutica europea plantea cambios en la regulación de los medicamentos...
Continuar leyendo
|
|

|

|
La inmunoterapia nivolumab se consolida en España con la financiación de seis nuevas indicaciones en tumores de pronóstico desfavorable y pocas opciones terapéuticas
La Comisión Interministerial de Precios de los Medicamentos (CIPM) ha aprobado la financiación de seis nuevas indicaciones...
Continuar leyendo
|
|

|

|
Artículos
|

|
Es posible detectar más de 50 trastornos congénitos a través de pruebas de cribado neonatal preventivas no invasivas
Gracias a las tecnologías avanzadas de cribado neonatal se puede conseguir recopilar muestras de manera eficiente, obtener resultados precisos y realizar...
Artículo completo
|
|

|

|
Estudio de la implementación de la tecnología de perfusión XCell ATF® para la intensificación de la producción de vacunas en MSD Animal Health
El número de productos biológicos a nivel mundial sigue creciendo y diversificándose. La aparición de modalidades más complejas,...
Artículo completo
|
|

|
ISO 14644-16. Llega la normativa para reducir el consumo energético en las salas blancas
El uso de las salas blancas va ganando terreno en la actualidad. Cada vez más sectores industriales y de investigación son conscientes de la importancia...
Artículo completo
|
|

|
Conociendo a... Histocell
Histocell comienza su andadura en la Universidad del País Vasco, en el Departamento de Biología Celular de la Facultad de Medicina. La idea original...
Artículo completo
|
|

|

|
Empresas premium
|


|
|
Este mensaje y sus adjuntos contienen información confidencial y reservada dirigida exclusivamente a su destinatario. Si ha recibido este mensaje por error, se ruega lo notifique inmediatamente por esta misma vía y borre el mensaje de su sistema. Nótese que el correo electrónico vía Internet no permite asegurar ni la confidencialidad de los mensajes que se transmiten ni la correcta recepción de los mismos. Los datos derivados de su correspondencia se incluyen en un fichero de titularidad de OMNIMEDIA, S.L. cuya finalidad exclusiva es gestionar las comunicaciones de la empresa entendiéndose que usted consiente el tratamiento de los mismos con dicha finalidad al mantener tal correspondencia. El ejercicio de sus derechos de acceso, rectificación, cancelación u oposición puede realizarlo dirigiéndose por escrito a la dirección C/ Pollensa, 2, Edif. Artemisa of. 12 de LA ROZAS (28290 - MADRID) adjuntando una fotocopia de su NIF o documento identificativo.
Este mensaje se ha enviado a {{ campaign.sender.email }} que está registrado dentro del listado de suscriptores de nuestra revista. Si no desea recibir más información y darse de baja de nuestros boletines click aquí
|